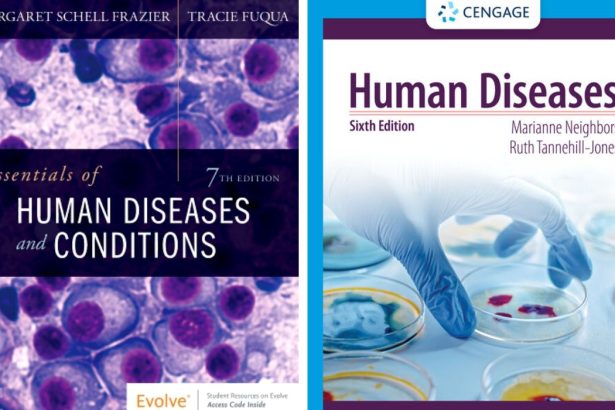
tadicurange disease

Latest Health News
Search
Have an existing account?
Sign In
© 2022 Foxiz News Network. Ruby Design Company. All Rights Reserved.
Health
Top Health News
TheLifestyleEdge com: A Complete Guide to Living Smarter, Happier, and More Balanced
In today’s fast-paced world, it’s easy to feel overwhelmed, stuck in routines, and disconnected from what truly matters. We all crave a life…
- Advertisement -